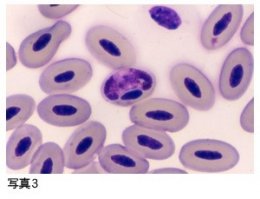

寄生虫検査
動物病院だより
動物園で飼育されている動物たちの健康管理のために、動物病院では毎日様々な検査が行われています。今回はその中で寄生虫検査をご紹介しましょう。
1.糞便寄生虫検査
材料が容易に手に入れることかでき検査効果も高いので、年に2回定期的に行っています。糞便検査は、顕微鏡を使って糞便中の寄生虫卵を見つけ(写真1)、その形態により主に消化管に寄生している親虫の種類を特定しますが、産卵数が少ない場合やある種の虫卵では、特殊な方法で虫卵を集めることもあります。また、虫卵の形態の似通った寄生虫では、培養して仔虫に成長させて観察します(写真2)。
その他に、チンパンジーではセロファンテープを使用して行う「蟯虫検査」があります。この方法は、皆さんが小学生のときに行った方法に似ています。ただ、チンパンジーの場合は、お母さんの変わりに飼育係のお兄さんがお尻を出させて、テープを肛門に軽く押しつけて行います。
2.血液検査
住血寄生虫の寄生を知る手段として重要です。哺乳類では、犬が蚊に刺されることで感染するフィラリア(犬糸状虫症)があります。フィラリアは心臓内で成虫となり、心臓のみならず他の臓器にも障害を引き起こします。犬ばかりでなく、食肉目や鰭脚目の野生動物(アライグマやアシカなど)も感染することがあるので、注意が必要です。診断は血液を顕微鏡で観察し、仔虫を見つけることによって行います。鳥類では、これも蚊が媒体となるペンギンの鳥マラリア症があります。寒い地方に住んでいるペンギンがマラリアに感染するなんてと思われるかもしれませんが、事実なのです。これはスライドグラスに薄く塗ってのばした血液を染色し、顕微鏡で観察してその寄生の有無を判定します(写真3)。
この他に、皮膚に寄生するダニなどの外部寄生虫を採取し、実体顕微鏡で観察することもあります。また、ある種の寄生虫では、抗体検査やエックス線検査が必要な場合があります。
これらの検査によって、寄生虫の早期発見とその治療を行うことが可能となります。様々な動物の糞便の臭いを嗅ぎながら、顕微鏡でミクロの世界をのぞく地道な仕事ですが、動物の健康維持に役立っていると思えば、ちょっと厳しい臭いにも耐えられるというものです。